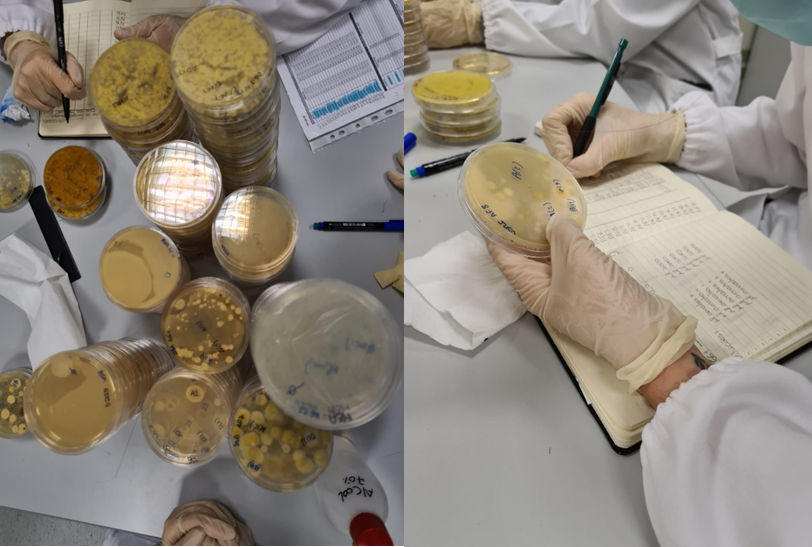

A Escola Superior de Saúde de Lisboa (ESSL) marca a sua posição a nível Nacional e Europeu em Saúde Pública ao integrar o Cluster IDEAL e em Saúde Ocupacional ao lançar um projeto pioneiro focado na saúde dos trabalhadores da indústria de triagem de resíduos.
O Cluster IDEAL é um consórcio europeu financiado pelo programa Horizon Europe, que reúne mais de 100 organizações provenientes de sete projetos dedicados à qualidade do ar interior (QAI) e aos seus impactos na saúde humana. Um dos sete projetos, o projeto InChildHealth, tem como missão integrar a investigação nas áreas da saúde, ambiente e ciências sociais com o propósito de identificar os fatores determinantes da QAI e avaliar o seu efeito em ambientes frequentados por crianças em idade escolar. A ESSL é responsável pela análise da contaminação microbiológica em escolas de sete países europeus. Esta intervenção engloba a avaliação de riscos, a proposta de medidas preventivas no âmbito da Saúde Ambiental, bem como a participação ativa em iniciativas de ciência cidadã e na divulgação dos resultados científicos ao longo do projeto.

Campanha de Amostragem nas escolas

Atividades de Ciência cidadã

Colaboração e participação em eventos de cariz científico
Em paralelo, a ESSL inicia o Projeto “Contributo para a Resolução dos Problemas de Saúde Ocupacional na Indústria da Triagem de Resíduos”. Este projeto visa aprofundar o conhecimento sobre os riscos específicos a que os profissionais do setor estão expostos, nomeadamente através da avaliação da exposição a microrganismos e substâncias químicas, e da análise dos efeitos na saúde resultantes de múltiplas exposições.
O projeto adota uma abordagem multidisciplinar, mobilizando o conhecimento de especialistas em Saúde Ambiental, Ciências Biomédicas Laboratoriais, Farmácia, Fisiologia Clínica e Matemática. Esta iniciativa ainda consolida parcerias estratégicas com outras entidades, como a Universidade NOVA de Lisboa e instituições internacionais de referência.
A concretização destes projetos reafirma o papel fulcral da ESSL como instituição que aposta na investigação e no desenvolvimento de soluções.